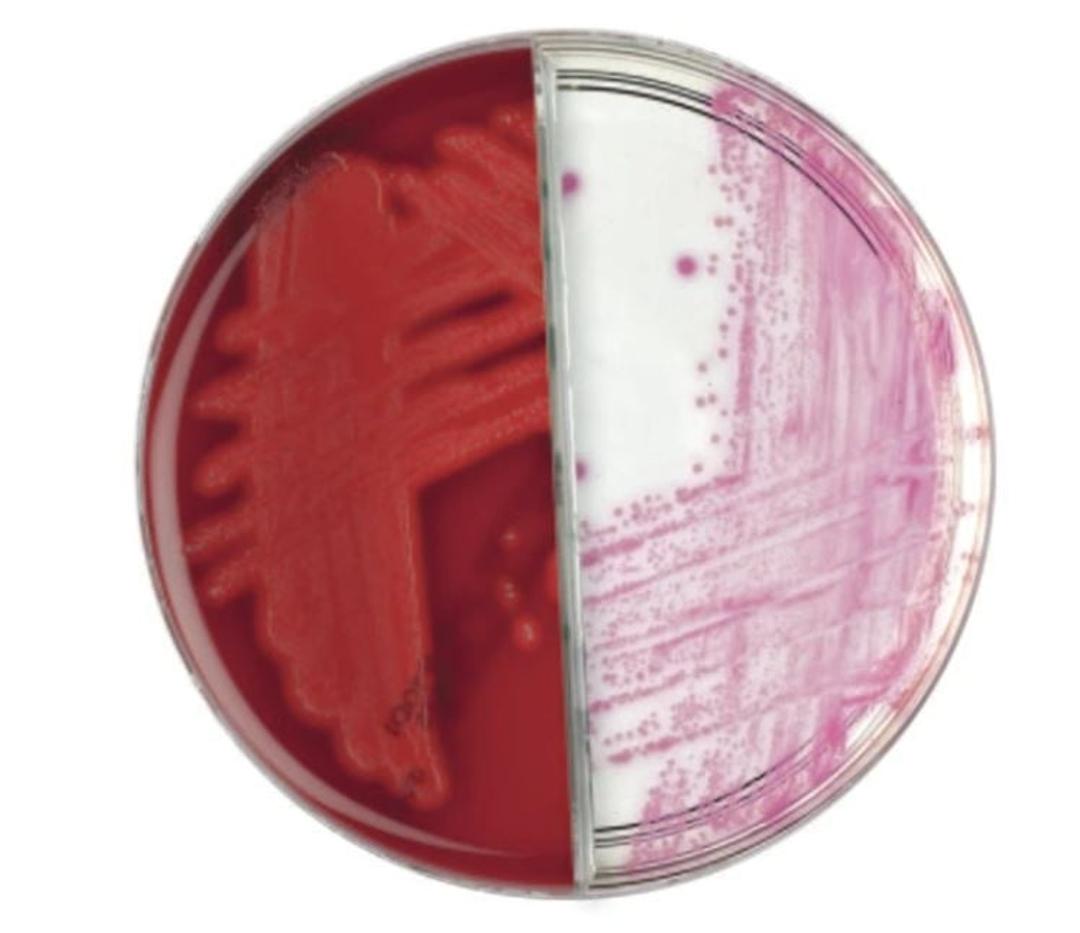
Thermo Scientific™ Oxoid™ Columbia CNA Agar/ Thermo Scientific™ Brilliance™ GBS Agar Biplate - Thermo Fisher Scientific - Life Sciences

Thermo Scientific™ Oxoid™ Columbia CNA Agar/ Thermo Scientific™ Brilliance™ GBS Agar Biplate
Combined in a biplate format, Thermo Scientific™ Oxoid™ Columbia CNA Agar/Thermo Scientific™ Brilliance™ GBS Agar enables simple screening of GBS and Gram positive organisms on one plate.

The supplier does not provide quotations for this product through SelectScience. You can search for similar products in our Product Directory.
Brilliance GBS Agar is a clear screening medium for the culture of GBS. The base medium is optimized to support excellent growth of GBS. This, together with antimicrobial components to suppress the growth of non-GBS organisms, make Brilliance GBS Agar a superior and robust medium solution for GBS screening.
The inclusion of Inhibigen™ technology makes Brilliance GBS Agar a highly selective medium for GBS screening with superior and reliable performance.
By combining this agar with a traditional medium, such as Columbia CNA
Agar, detection is not limited to GBS, and Gram positive organisms can also be identified. The combination of media allows laboratories to a get a full clinical picture from one sample on GBS and Gram positive organisms.
Application: Simplified screening of low vaginal swabs (LVS), high vaginal swabs (HVS), vaginal or recto-vaginal samples for GBS and staphylococci/streptococci
Battling antimicrobial resistance: Innovations and strategies in modern healthcare
Antimicrobial resistance (AMR) is at the heart of a growing global crisis, as hospitals increasingly face infections that were once manageable but are now difficult to treat due to resistance to traditional antibiotics.
Download the new eBook and explore a systems-based approach in tackling antimicrobial resistance (AMR). Learn about key problematic pathogens, and gain insights into effective strategies for screening, detection, and testing of multidrug-resistant organisms (MDROs) to support healthcare professionals and laboratories in addressing this growing challenge.
Going green: Where are we on the sustainable microbiology lab journey?
In this guest editorial, discover the solutions that are driving the green revolution to make clinical laboratories more sustainable